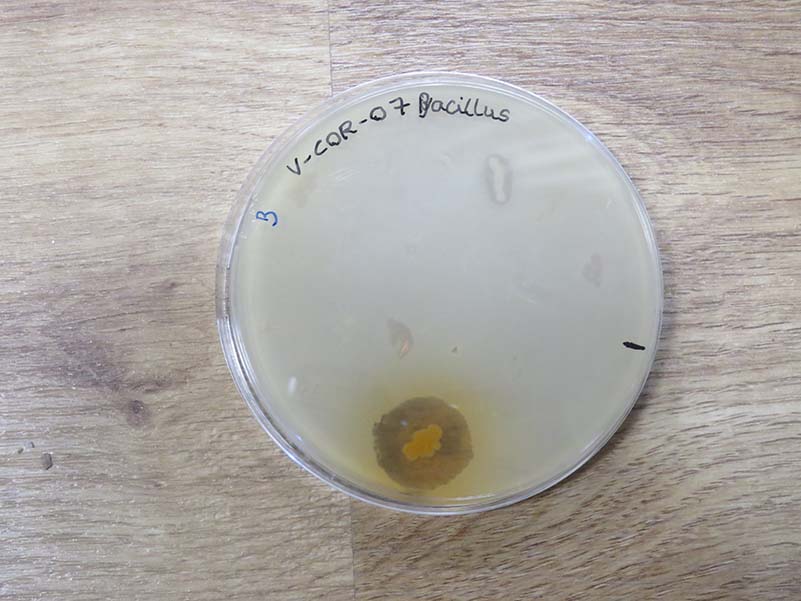

- Aquest mes l’IES Joan Coromines va participar al projecte Micromón de la Universitat de València. Al llarg de diferents sessions de treball de camp i laboratori, l’alumnat ha preparat i seleccionat cultius de bacteris per ajudar al desenvolupament de nous antibiòtics.
Els bacteris, moltes vegades generen substàncies per combatre altres bacteris, i per això poden ser uns bons aliats en la lluita contra els microorganismes que generen malalties humanes.
Una vegada finalitzades les pràctiques al nostre centre, amb l’assessorament del personal de la UV, el nostre alumnat va poder trobar un grup de bacteris que podrien ser seleccionades per la seua acció antibiòtica davant altres bacteris. Ara, els i les investigadores de la Universitat de València continuaran el projecte tractant de trobar substàncies que es puguen convertir en nous medicaments.
A més, d’ací a poc publicarem les entrevistes realitzades als investigadors/es del projecte. I al maig, podrem participar com a convidats/des del projecte a les instal·lacions del campus de Burjassot-Paterna, a València, per celebrar el final del projecte.
Aquesta pràctica ha sigut una experiència molt motivadora i innovadora, que ha implicat al nostre alumnat en un projecte de ciència ciutadana, per demostrar que es pot fer ciència, sense la necessitat de grans laboratoris, entre tots i totes, per assolir un objectiu comú: ajudar a les persones.
Moltíssimes gràcies a totes les persones participants! Esperem repetir l’any vinent!





















